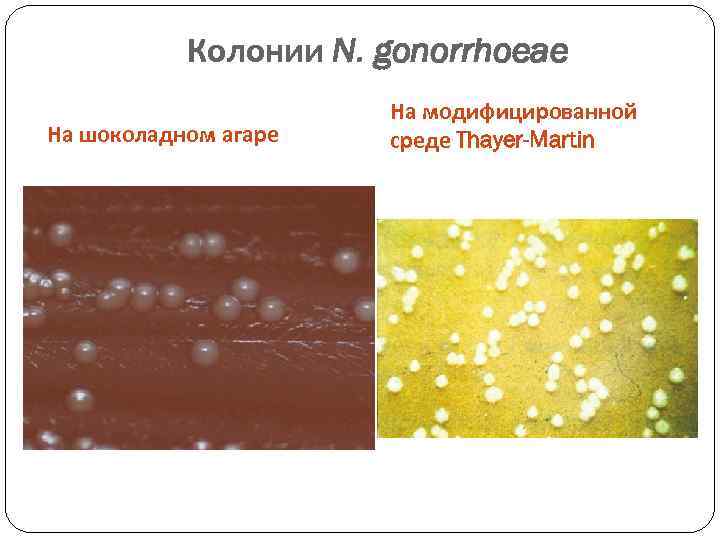
Колонии N. gonorrhoeae На шоколадном агаре На модифицированной среде Thayer-Martin

Вен заб.ppt
- Количество слайдов: 77

ВЕНЕРИЧЕСКИЕ ЗАБОЛЕВАНИЯ Занятие 1 СЗГМУ, 2012

Сифилис – венерическое заболевание с длительным рецидивирующим течением, в ходе которого происходит смена нескольких периодов с разными клиническими проявлениями. При сифилисе могут поражаться практически все системы и органы

Таксономическое положение возбудителя сифилиса Семейство Spirochaetaceae Род Treponema Вид Treponema pallidum Подвиды T. pallidum – возбудитель сифилиса T. endemicum – возбудитель беджель T. carateum – возбудитель пинты T. pertenue – возбудитель фрамбезии

Окраска по Романовскому-Гимзе Трепонемы (лат. сгибающаяся, вращающаяся нить) – тонкие спиралевидные грамотрицательные прокариоты. Среднее количество завитков 8 -12. Снаружи трепонема иногда покрыта слизистым чехлом типа псевдокапсулы из кислых полисахаридов, спор не образует. Размножается бинарным делением. Формы выживания: цистовая (сворачивается в клубочек и образует вокруг себя непроницаемую оболочку), L-форма, зернистые формы

Электронная микроскопия. Увеличение 131000. Подвижность обеспечивает внутриклеточный аппарат движения: пучки миофибрилл, обвивающие тело трепонемы. Крепятся к базальным телам у полюсов клетки ч - чехол; б - блефаропласт; ф - фибрилы


Трепонема, окрашенная методом серебрения по Морозову

Сапрофитические спирохеты (Spirocheta buccalis) в мазке из зубного налета; окраска по Граму .

Культивирование T. pallidum Бледная трепонема не растет на искусственных питательных средах, ее культивируют, заражая кроликов-самцов в ткань яичка, где развивается воспалительный процесс (орхит) и накапливается большое количество вирулентных «тканевых» трепонем.

Антигены T. pallidum Белковый антиген, высокоиммуногенный. , термостабильный. Антитела к нему появляются в конце инкубационного периода или в течение первой недели после появления твердого шанкра. Длительно сохраняются после излечивания. Полисахаридн антиген, малоиммуногенный , термостабильный. Антитела к нему в диагностике не имеют значения. Липидный «вездесущий» антиген, иммуногенный, на его долю приходится около 30% сухого вещества клетки спирохеты. Имеет сходство с фосфолипидами митохондриальных мембран тканей человека. Антитела к нему называются реагинами - они появляются на 5 -6 неделе после заражения и исчезают после успешного лечения.

Факторы патогенности T. pallidum Адгезин – поверхностный белок, взаимодействует с фибронектином слизистой. Инвазивность - обеспечивает спиралевидная форма и подвижность Антифагоцитарные свойства - способность связывать на своей поверхности фибронектин Поверхностные липопротеины могут участвовать в активации воспаления Способность размножаться в межклеточном пространстве и поражать эндотелий сосудов Способность к антигенным вариациям – ускользание от иммунного ответа

Источник и пути передачи Источник – больной человек Путь заражения Характеристика Половой путь Основной путь инфицирования, при нарушении целостности кожных покровов и слизистых оболочек Контактно-бытовой при поцелуях, укусах, кормлении грудью, а также при профессиональных прямых контактах медицинского персонала. Гемотрансфузионный При переливании крови больного сифилисом (трансплантации) Трансплацентарный Инфицирование происходит через сосуды пораженной плаценты в период беременности и ведет к внутриутробному заражению сифилисом плода.


Периоды заболевания сифилисом Классическое течение сифилиса в виде первичного, вторичного и третичного периодов наблюдается у больных при отсутствии лечения. В настоящее время сифилис излечивается в первичном или вторичном периоде.

Периоды заболевания сифилисом и методы лабораторной диагностики Первичный период – твердый шанкр - безболезненный воспалительный процесс в месте входных ворот инфекции в виде небольшой эрозии или язвы на плотном основании. В тканевом отделяемом содержится много трепонем. Через 3 -4 недели в сыворотке появляются антитела.

Периоды заболевания при сифилисе – вторичный период Вторичный сифилис продолжается 2 -3 года. В результате генерализация инфекции в процесс вовлекаются кровеносные сосуды, лимфатическая система, внутренние органы, костная система, ЦНС. Течение рецидивирующее, приступообразное. На коже и слизистых оболочках появляются различные высыпания, содержащие множество трепонем. Высыпания продолжаются 1, 5 -2 месяца, затем исчезают и вновь появляются. Серологические реакции на протяжении всего периода положительные

Вторичный сифилис

Третичный период сифилиса Третичный период – наиболее тяжелый, имеет рецидивирующее течение, продолжается многие годы. Трепонемы не всегда обнаруживаются. Развивается ГЗТ. Для этого периода характерны сифилитические гранулемы – гуммы, они склонны к некрозу и распаду, при их заживлении образуются грубые втянутые рубцы и участки склерозированной ткани. Гуммы могут образовываться в любых органах и тканях, в том числе и в жизненно важных. Серологические реакции положительны менее чем у 70% больных.

Третичный сифилис

Осложнения Ранние осложнения (первичный и вторичный сифилис) Гангрена и самоампутация полового члена Ранний нейросифилис: сифилитический менингоневрит с поражением слухового и зрительных нервов (с последующей их атрофией - слепотой и глухотой) Поражение яичек (сифилитический орхоэпидидимит) Поражение печени и почек Косметические осложнения - сыпь, выпадение волос, образование рубцов на месте шанкров Осложнения во время беременности Преждевременное прерывание беременности Смерть плода Ранний врожденный сифилис и смерть новорожденного Поздний врожденный сифилис ведущий к инвалидности и ранней смерти

Поздние осложнения (поздний скрытый сифилис, третичный сифилис) Осложнения, которые могут привести к смерти больного: Сифилитический аортит Сифилитическая аневризма аорты Сифилитический пневмосклероз и бронхоэктазия Осложнения, приводящие к инвалидности больного: Перфорация твердого неба (невозможность приема пищи) Седловидный нос (затруднение дыхания) Гуммозные периоститы, оститы и остеомиелиты (ограничение передвижения) Осложнения, приводящие к стойким психоневрологическим расстройствам: (Поздний нейросифилис) Поздний менинговаскулярный сифилис с поражением зрительного и слухового нервов Сухотка спинного мозга Прогрессивный паралич

Особенности иммунитета Иммунитет нестерильный В его формировании участвуют гуморальные и клеточные факторы, развивается ГЗТ Незавершенный фагозитоз Образуются специфические АТ – реагины (антилипидные) и специфические (антитрепонемные) После истечения заболевания иммунитет не сохраняется

Лабораторное исследование при подозрении на сифилис Методы диагностики: Микроскопический Серологический

Микроскопическое исследование проводят в первичном и вторичном периоде сифилиса. Исследуемый материал: отделяемое твердого шанкра, язв, эрозий, содержимое разных высыпаний на коже или слизистых оболочках и др. Применяют темнопольную микроскопию, реже окрашивают препараты

Treponema pallidum Serous transudate from moist mucocutaneous primary chancre. Direct immunofluorescence.

Серологическая диагностика сифилиса Серологические реакции применяют для выявления АТ. Они подразделяются на: - Неспецифические – выявляющие противолипидные АТ (реагины), в них используют неспецифический кардиолипиновый антиген. - Специфические – в них используют специфические трепонемные антигены.

Серологическая диагностика сифилиса (продолжение) Серологическая диагностика сифилиса проводится в нашей стране согласно приказу № 87 МЗ РФ от 26. 03. 2001 г с применением следующих тестов: - Отборочные (скрининговые) тесты - Подтверждающие тесты.

Отборочные серологические тесты Антиген - стандартный кардиолипин-лецитин -холестероловый антиген и ультразвуковой дезинтеграт культуральных трепонем (трепонемный антиген). Нетрепонемные тесты, в связи с дешевизной, доступностью простотой и быстрым сроком исполнения, применяются для скрининга сифилиса как отборочные реакции. По изменению количественных нетрепонемных тестов судят о степени эффективности лечения сифилиса и устанавливают его излеченность. П оэтому нетрепонемные тесты применяются в комбинации с трепонемными тестами для установки диагноза сифилиса и проводятся до начала лечения, в процессе лечения и после окончания лечения в определенные временные интервалы. Снижение титров нетрепонемных тестов в 4 и более раза в течении года после лечения подверждает эффективность проведенной терапии 1. Реакция микропреципитация (РП) или ее сифилиса и является критерием его излеченности модификации (РПР и др. )

Механизм реакции микропреципитации с кардиолипиновым антигеном

Не-трепонемные тесты РПР Принцип Основан на использовании угольных частиц, покрытых кардиолипиновым антигеном для определения антикардиолипиновых антител в сыворотке или плазме + Угольные частицы, покрытые кардиолипиновым Аг Антикардиолипиновые Ат образца Положительная реакция: темные крупные агрегаты кардиолипиновых частиц

РПР - тест 1. Отрицательный результат 2. Положительный? 3, 4. Положительный Ложноположительные результаты в отборочных тестах : беременность, прием накануне жирной пищи или алкоголя, острые воспалительные процессы, инфаркт, переломы, туберкулез, цирроз, аутоиммунные заболевания и др.

Не-трепонемные тесты РПР Содержание набора (РПР 100) Слайды для реакции Кардиолипиновый антиген Положительный и Отрицательный Контроли Флаконкапельница и игла

Подтверждающие серологические тесты В качестве антигенов применяются трепонемные антигены - либо интактные трепонемы либо очищенные и ультраозвученные трепонемы либо рекомбинантные антигены Трепонемные тесты применяются только для диагностики сифилиса и не используются для проведения контроля излеченности. 1. РПГА (РНГА) – реакция пассивной (непрямой) гемагглютинации 2. ИФА – иммуноферментный анализ 3. РИФ – реакция иммунофлюоресценции с адсорбцией 4. Иммуноблот 5. РИТ – реакция иммобилизация трепонем

Трепонемные тесты РПГА Принцип Используются птичьи эритроциты, покрытые антигеном T. pallidum для определения антител в сыворотки или плазме + Куринные эритроциты T. pallidum Аг Образец с анти-T. pallidum АТ Положительные образцы – пассивная гемоагглютинация

Трепонемные тесты РПГА Интерпретация ++++ ++ Положительные + - -- --- Отрицательные Неопределенные Можно проводить полуколичественные исследования

Трепонемные тесты РПГА Содержание набора (РПГА 200) Положительный и отрицательный контроли Буфер для разведения Эритроциты с сорбированным антигеном Контрольные клетки

Непрямой иммунофлуресцентный метод

ИФА. Определение антител в сыворотке больного с сорбированным антигеном

Альберт Людвиг Нейссер (1855 -1916) НЕЙССЕР (Neisser) Альберт Людвиг (1855 -1916), немецкий дерматовенеролог. Открыл (1879) возбудителя гонореи. Разработал (совместно с А. Вассерманом) метод серологической диагностики сифилиса.

Гонорея - острое воспаление мочеиспускательного канала у мужчин, уретры и шейки матки у женщин обычно сопровождается выделением наружу гноя.

Neisseria gonorrhoeae Относится к патогенным микроорганизмам Инфекции: Острая Хроническая (L-трансформация) Бессимптомная (70 -80% у женщин, 5 -10% у мужчин) Осложнения: Гонококковый сепсис Осложнения любых органов Кожные поражения

Гонобленнорея новорожденных и поражение слизистой глаза взрослого человека гонококками (греч. blenna - слизь и reo - теку)

ГОНОКОККИ Морфология N. gonorrhoeae Длина: 1, 25 -1, 6 мкм Ширина: 0, 7 -0, 9 мкм ПЭМ, Ультратоний срез. А) бинарное деление гонококка; Б) гонококки на поверхности эпителиальной клетки

Факторы патогенности Neisseria gonorrhoeae Факторы вирулентности Биологический эффект • Пили (белок пилин) (Пили IV типа – токсич. эффект) Прикрепление гонококков к эпителию (уретры, влагалища, фаллопиевых труб, полости рта, конъюнктивы) • Капсула Антифагоцитарная активность Белки наружной мембраны: • Протеин I (Por-пориновый белок) • Протеин II (Ора — Opacity protein; Opacity — мутность), т. е. протеин мутности; • Протеин III (Rmp — Reduction modifiable protein) • • Способствует внутриклеточному выживанию бактерий, препятствуя слиянию лизосом с фагосомой нейтрофилов Опосредует плотное прикрепление к эпителиальным клеткам и инвазию внутрь клеток Защищает поверхностные антигены (Рог-белок, липоолигосахарид) от бактерицидных антител ЛПС Липополисахарид обладает свойствами эндотоксина, подавляет рост других микроорганизмов – явление «стерильного гноя» Бета –лактамаза (не у всех) Гидролизует бета-лактамное кольцо пенициллинов

Лабораторная диагностика: 1. 2. 3. 4. Морфология – диплококки (кофейные зерна, пчелиный рой) Гр(-) бактерии Эндоцитобиоз (внутри нейтрофилов, клеток цилиндрического эпителия) ПЦР (для ротовой полости и прямой кишки не использовать) Поражено 1 -2% нейтрофилов – начало заболевания Поражено 12 -20% нейтрофилов –разгар заболевания

Возбудитель гонореи в мазке гноя Окраска метиленовым синим. Окраска по Граму

Лабораторная диагностика: Условия для культивирования N. gonorrhoeae. : 37 о. С сыворотка крови или цельная кровь асцитическая жидкость 10 -20 % углекислого газа р. Н 7, 2 -7, 8
Колонии N. gonorrhoeae На шоколадном агаре На модифицированной среде Thayer-Martin

Выделение культуры ( «золотой стандарт» диагностики гонореи) Колонии гонококков на среде «BIOCULT» (инкубация 72 часа) после пероксидазной реакции

Gram stain of a culture of N. gonorrhoeae showing the gram-negative cocci occurring most in pairs; some have formed clumps during the staining procedure (. 1, 000).

Биохимическая активность N. gonorrhoeae Изменение цвета индикатора с красного на желтый в пробирке с глюкозой.

Всемирная Организация Здравоохранения рекомендует 4 схемы лечения гонореи: 1) ципрофлоксацин 2) цефтриакcон 3) цефиксим 4) спектиномицин Эти схемы предусматривают однократное назначение препарата.

Тип Polymastigota – наибольшее медицинское значение имеют трихомонады и лямблии.

Трихомониаз - заболевание мочеполовой системы, вызываемое простейшим одноклеточным паразитом Trichomonas vaginalis. Заболевание передаётся половым путём и, в крайне редких случаях, возможно заражение через контаминированные поверхности. Болезнь не имеет сезонного характера, поражает все слои населения. Несмотря на интенсивное изучение, имеются определённые трудности в диагностике трихомониаза и его лечении.

Инфекционным агентом трихомониаза человека (синонимы – трихомоноз, трихомонадоз) является исключительно Trichomonas vaginalis. По систематике одноклеточное простейшее Trichomonas vaginalis относится к царству высших процистов - Protozoa, классу жгутиковых - Flagella, семейству - Trichomonadidae, роду – Trichomonas. Человек может быть носителем трёх видов трихомонад: Trichomonas tenax (elongata), Trichomonas hominis (abdominalis), Trichomonas vaginalis. В ротовой полости на кариозных зубах обитает Trichomonas tenax. При диспепсических расстройствах, обычно у детей и реже у взрослых, выделяют комменсал толстого кишечника - Trichomonas hominis. Трихомонадой, живущей в урогенитальном тракте, считается исключительно Trichomonas vaginalis.

В чистой культуре Trichomonas vaginalis имеет овальную или округлую форму длиной 10 мкм и шириной 7 мкм. Внешний вид клетки меняется в зависимости от физикохимических условий среды и роста. Когда трихомонада прикрепляется к эпителиальной клетке, она приобретает амёбовидную форму. T. vaginalis - это одноклеточный простейший организм. Он имеет пять жгутиков, четыре из которых расположены в его передней части, а пятый жгутик располагается внутри ундулирующей мембраны, совершающей волнообразные движения. Жгутики и ундулирующая мембрана создают паразиту характерные дрожащие движения. Причём по длине ундулирующей мембраны при микроскопии можно отличить T. vaginalis от кишечной трихомонады T. hominis, которую иногда находят в моче у детей.

Ядро T. vaginalis расположено в его передней части и, как у других эукариот, окружено пористой ядерной мембраной. Трихомонада имеет диплоидный набор хромосом 2 n=6. В 1997 г. было дано морфологическое описание каждой пары хромосом, что очень важно для генетического картирования и клонирования Тонкий гиалин палочкоподобной структуры, который начинается в ядре и пересекает вдоль всю клетку, называют аксостилем. Он находится в задней части паразита, заканчиваясь острым концом. Считается, что эта структура способствует первичному прикреплению паразита на эпителиальных клетках мочеполовых путей.


An electron micrograph depicts the Trichomonas vaginalis parasite adhering to vaginal epithelial cells collected from vaginal swabs. A non-adhered parasite (right) is pearshaped, whereas the attached parasite is flat and amoeboid. Image courtesy of: Antonio Pereira-Neves and Marlene Benchimol, Santa Ursula University, Rio de Janeiro, Brazil.

У живых клеток в световой микроскоп видны гранулы. Они продуцируют молекулярный водород и были названы гидрогеносомами. Существует два типа этих гранул: паракостальные и паракостилярные. Последние располагаются вдоль аксостиля тремя параллельными рядами, которые являются отличительной чертой T. vaginalis. Клеточный лизат имеет гидролазную активность и содержит лизосомоподобные структуры, такие как фагосомы. В настоящее время считается, что T. vaginalis, как и многие другие простейшие паразиты, существует только как трофозоид, утративший стадию цистообразования.


T. vaginalis - это облигатный паразит, у которого потеряна способность синтезировать многие макромолекулы de novo, особенно пурины, пиримидины и многие липиды. Эти питательные компоненты микроорганизм получает из вагинального секрета или при фагоцитозе бактериальных клеток нормальной микрофлоры мочеполовых путей. Поэтому в культуральную среду для T. vaginalis необходимо включать все важнейшие макромолекулы, витамины и минералы. Для роста трихомонад особенно важна сыворотка крови, поскольку она содержит липиды, жирные кислоты, аминокислоты и следы металлов. Присутствие эукариотических клеток необходимо для культур без сыворотки. In vitro T. vaginalis растёт оптимально при р. Н 6, 0 -6, 3 и температуре 35 -37 С, хотя её рост осуществляется и в более широком диапазоне р. Н, особенно в изменяющейся среде влагалища.



КЛИНИЧЕСКАЯ КАРТИНА УРОГЕНИТАЛЬНОГО ТРИХОМОНИАЗА Клинические проявления урогенитального трихомониаза отличаются большим разнообразием, от острых форм с ярко - выраженными симптомами воспаления до мало – и асимптомного течения заболевания. Патогномоничных клинических (субъективных и объективных) признаков трихомониаза не существует, также как не существует специфических морфологических изменений в пораженных органах и тканях. Вопрос о специфичности воспаления, вызванного влагалищной трихомонадой также остается открытым до настоящего времени.

Инкубационный период 5 - 15 дней Острая манифестная инфекция: Острый трихомониаз проявляется у женщин в виде вагинита. Основные симптомы: • обильные выделения, раздражающие кожу наружных половых органов • болезненное мочеиспускание • губки уретры отёчны и гиперемированы • при осмотре обнаруживается небольшая гиперемия свода влагалища и шейки матки, но возможны и обширные эрозии

Инкубационный период 5 - 15 дней Острая манифестная инфекция: Острый трихомониаз проявляется у мужчин в виде уретрита Основные симптомы: • обильные гнойные выделения или серые при подостром • болезненное мочеиспускание • губки уретры отёчны и гиперемированы

ЛАБОРАТОРНАЯ ДИАГНОСТИКА ТРИХОМОНАДНОЙ ИНФЕКЦИИ Диагностика урогенитального трихомониаза основывается на выявлении клинических признаков заболевания и обнаружении в исследуемом материале T. vaginalis. В связи с изменением стереотипов сексуального поведения в последнее время (промискуитет, увеличение частоты орально-генитальных и анально-генитальных контактов) необходимо учитывать возможность определения в урогенитальном тракте больных трихомониазом других видов трихомонад - Trichomonas tenax (elongata), Trichomonas hominis (abdominalis). Например, отечественными авторами при электронномикроскопическом исследовании материала прямой кишки при мочеполовом трихомониазе были обнаружены T. vaginalis, что подтверждает возможность смены простейшими привычной среды обитания и колонизации новой экологической ниши.

Диагностика трихомониаза основывается на классических симптомах, включающих жёлтозелёные пенистые выделения, зуд, дизурию, диспарению и "клубничный" вид шейки матки и вагины, представляющий собой точечные геморрагии. Тем не менее, диагноз не может быть поставлен исключительно на основании клинической картины по нескольким причинам: - указанные клинические симптомы могут быть проявлениями других инфекций урогенитального тракта; - классический и патогномоничный для трихомониаза "клубничный" симптом встречается только у 2% пациенток; - пенистые выделения, которые можно связать с активным ростом трихомонад, наблюдаются примерно у 12% инфицированных женщин.

В настоящее время в России и за рубежом применяют четыре лабораторных метода определения Trichomonas vaginalis: микроскопический, культуральный, иммунологический и генодиагностический. Микроскопический метод включает две методики. Первая - это определение трихомонад в нативном препарате при фазовом контрастировании. Необходимо найти овальное или грушевидное тело, чуть больше лейкоцита, имеющее жгутики и совершающее характерные толчкообразные поступательные движения. Такое исследование следует делать практически "не отходя от пациента", иначе в течение нескольких минут влагалищная трихомонада может прекратить свои движения. Вторая методика - это окрашивание препарата метиленовым синим (как вариант: раствором бриллиантовой зелени) или по Граму. Ведётся поиск известной формы трихомонады с правильно очерченным асимметричным ядром на фоне нежно ячеистой структуры цитоплазмы. Для выявления жгутиков и ундулирующей мембраны препарат следует окрашивать по Романовскому-Гимзе.


Чувствительность метода микроскопии по данным литературы варьирует от 38% до 82%. Несмотря на то, что этот метод среди диагностических тестов является определённо экономически наиболее целесообразным и простым, он имеет низкую чувствительность и специфичность. Это может быть обусловлено, в первую очередь, потерей трихомонадами характерной подвижности после того, как простейшее уже извлечено из среды человеческого организма. Особенно большая доля субъективизма проявляется в случае препаратов с низким титром или препаратов, содержащих огромное количество клеток эпителия, лейкоцитов и различного деструктивного материала из очага поражения. В очаге поражения влагалищная трихомонада часто представлена округлыми формами, напоминающими полиморфоядерные лейкоциты, и естественно, типичные морфологические признаки теряются во время фиксации и окрашивания, создавая трудность для этиологической идентификации.

Метод выращивания трихомонад в бульонной культуре - "золотой стандарт" для диагностики, потому что это простой в интерпретации метод и требует менее чем 300500 трихомонад/мл инокулюма для начала роста в культуре. Тем не менее, для него существуют ограничения, присущие культуральным методам. Для диагностики необходим инкубационный период от 5 до 7 дней, являющийся слишком длительным из-за возможности инфицированного пациента к распространению инфекцию. В связи с этим он не получил широкого применения в клинической практике в качестве прямого диагностического метода.

Для улучшения восприятия культурального метода, за рубежом был разработан метод пластикового конверта, с помощью которого можно выполнить как немедленную проверку присутствия трихомонады, так и сохранить дальнейший рост трихомонад в одной самоподдерживающейся системе. Полученные результаты сравнимы с таковыми при исследовании мазка и культур. Аналогично пластиковому конверту используется система In. Pouch в виде двухкамерного мешка, позволяющая выполнить быструю проверку культуры путём микроскопии через стенку мешка. Технология роста патогена на клеточной культуре использует свойства клеточных линий восстанавливать рост T. vaginalis из клинических образцов. Было продемонстрировано, что этот метод даёт лучшие результаты- относительно культивирования в бульоне и приготовления влажной камеры, поскольку способен определять T. vaginalis в концентрациях менее 3 организмов в 1 мл. Однако культивирование в культуре - это не простой рутинный метод; он дорог и неудобен для быстрой диагностики.

ЛЕЧЕНИЕ УРОГЕНИТАЛЬНОГО ТРИХОМОНИАЗА До 1959 года местные вагинальные препараты, включая лекарственные средства принятые в народной медицине, воздействующие на трихомонаду, давали незначительное улучшение при определённых клинических проявлениях болезни, но не вызывали полного уничтожения (эрадикации) паразита в мочеполовых путях человека. Применяемые в то время препараты не санировали эпителий влагалища и уретры, бартолиниевые железы и простату, которые были основной средой обитания возбудителя трихомониаза. Даже если женщины лечились успешно, то их половые партнёры ввиду скудности клинической симптоматики, как правило, не лечились вообще или лечились недостаточно, следствием чего являлась реинфекция. Большинство современных интравагинальных препаратов также паллиативны в отношении T. vaginalis и их эффективность в качестве главного лечебного средства не является выраженной.

Новая эра в терапии урогенитального трихомониаза началась в 1959 году, когда впервые было синтезировано нитроимидазольное производное антибитика "азомицина" из Streptomyces - высокоэффективное синтетическое средство для лечения данного заболевания. Полное химическое название этого антибиотика альфа, бета-гидроксиэтил-2 -метил-5 -нитроимидазол под общим названием "метронидазол" и продаваемого под торговом наименованием "Флагил" или "Трихопол" в России. Другие нитроимидазолы разрешённые для клинического применения в разных странах мира - это тинидазол, орнидазол, секнидазол, флюнидазол, ниморазол, карнидазол.

лечение антибиотиком Cl. trachomatis N. gonorrhoeae
Вен заб.ppt